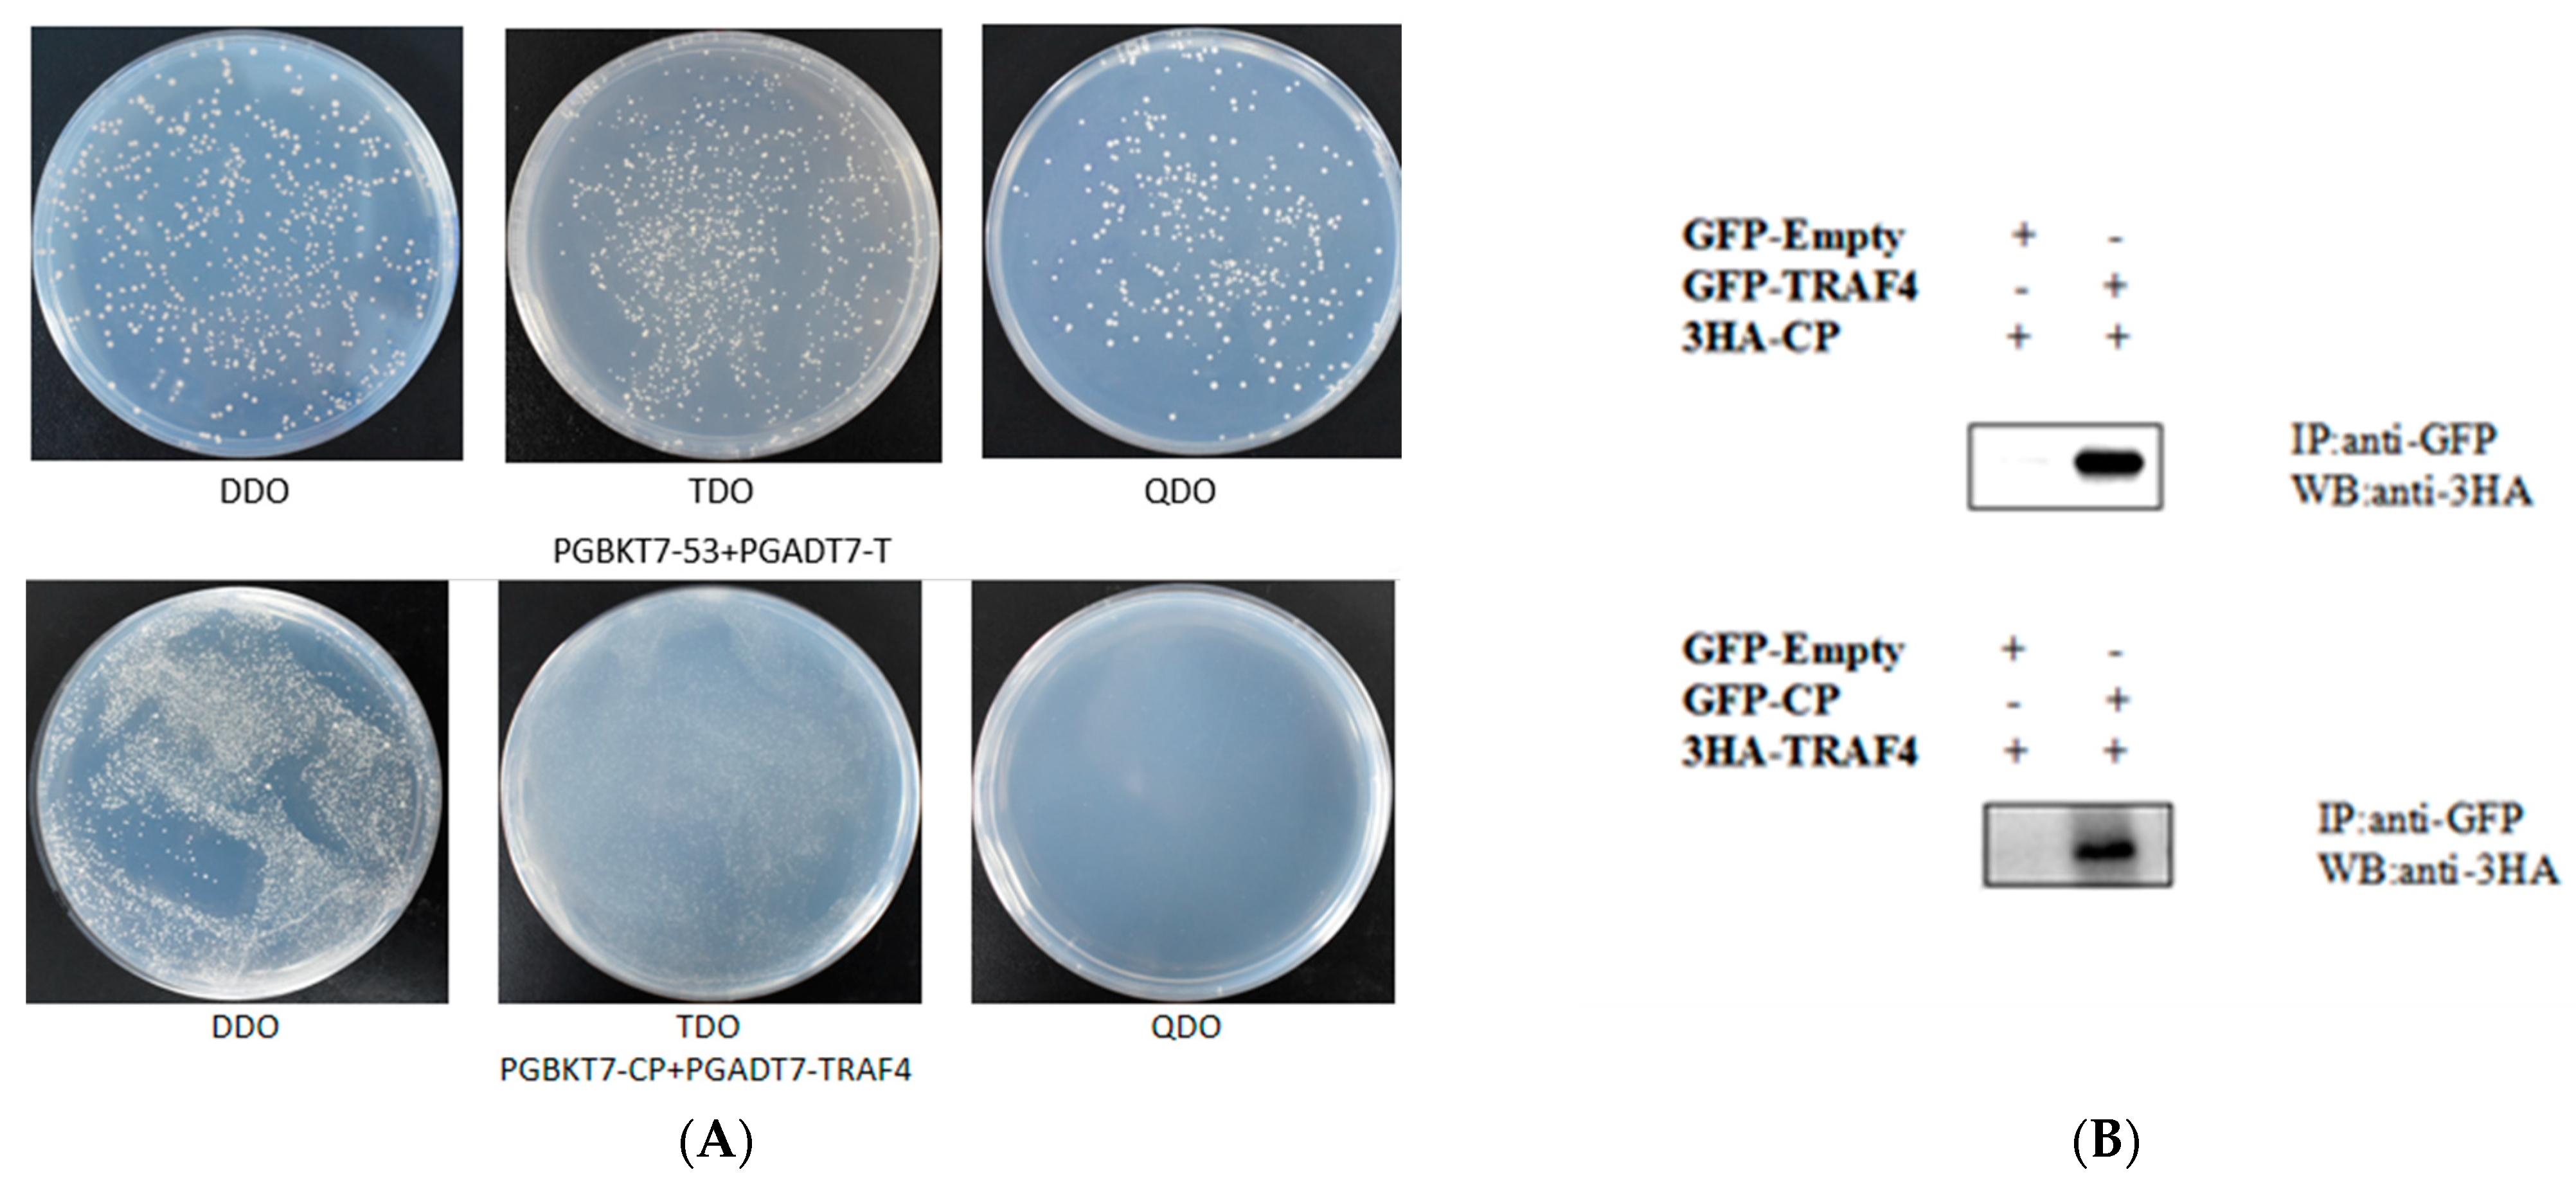
Ijms 22 06136 g007

Grouper TRAF4, a Novel, CP-Interacting Protein That Promotes Red-Spotted Grouper Nervous Necrosis Virus Replication
Abstract
1. Introduction
2. Results
2.1. Identification and Sequence Analysis of EcTRAF4
2.2. Tissue Expression Analysis of EcTRAF4
2.3. Intracellular Localization of EcTRAF4
2.4. EcTRAF4 Overexpression Promotes RGNNV Replication
2.5. EcTRAF4 Knockdown Inhibits RGNNV Replication
2.6. RGNNV CP Interacts with EcTRAF4
2.7. RGNNV or CP Promotes EcTRAF4 Expression
2.8. EcTRAF4 Is a Negative Regulator of Virus-Induced IFN Signaling
3. Discussion
4. Materials and Methods
4.1. Fish, Cell Lines, and Virus
4.2. RNA Isolation, cDNA Synthesis, and RT–qPCR
4.3. Cloning of EcTRAF4 and Sequence Analysis
4.4. Plasmid Construction
4.5. Cell Transfection
4.6. Cellular Localization Analysis
4.7. Viral Infection Assays and Sample Collection
4.8. Small Interfering RNA (siRNA)-Mediated EcTRAF4 Knockdown
4.9. Coimmunoprecipitation Assays and Western Blotting
4.10. Yeast Two-Hybrid Analysis
4.11. RT–qPCR Analysis of Relative Expression Levels of host and Viral Genes
4.12. Dual-Luciferase Reporter Assays
4.13. Statistical Analyses
4.14. Ethics Statement
Author Contributions
Funding
Institutional Review Board Statement
Informed Consent Statement
Data Availability Statement
Conflicts of Interest
References
- Zhu, Z.M.; Dong, C.F.; Weng, S.P.; He, J.G. The high prevalence of pathogenic Vibrio harveyi with multiple antibiotic resistance in scale drop and muscle necrosis disease of the hybrid grouper, Epinephelus fuscoguttatus (female symbol) × E. lanceolatus (male symbol), in China. J. Fish Dis. 2018, 41, 589–601. [Google Scholar] [CrossRef] [PubMed]
- Qin, Q.W.; Chang, S.F.; Ngoh-Lim, G.H.; Gibson-Kueh, S.; Shi, C.Y.; Lam, T.J. Characterization of a novel ranavirus isolated from grouper Epinephelus tauvina. Dis. Aquat. Org. 2003, 53, 1–9. [Google Scholar] [CrossRef] [PubMed]
- Wei, J.G.; Huang, Y.H.; Zhu, W.B.; Li, C.; Huang, X.H.; Qin, Q.W. Isolation and identification of Singapore grouper iridovirus Hainan strain (SGIV-HN) in China. Arch. Virol. 2019, 164, 1869–1872. [Google Scholar] [CrossRef] [PubMed]
- Hegde, A.; Chen, C.; Qin, Q.; Lam, T.; Sin, Y. Characterization, pathogenicity and neutralization studies of a nervous necrosis virus isolated from grouper, Epinephelus tauvina, in Singapore. Aquaculture 2002, 213, 55–72. [Google Scholar] [CrossRef]
- Shetty, M.; Maiti, B.; Santhosh, K.S.; Venugopal, M.N.; Karunasagar, I. Betanodavirus of Marine and Freshwater Fish: Distribution, Genomic Organization, Diagnosis and Control Measures. Indian J. Virol. 2012, 23, 114–123. [Google Scholar] [CrossRef]
- Toffan, A.; Pascoli, F.; Pretto, T.; Panzarin, V.; Abbadi, M.; Buratin, A.; Quartesan, R.; Gijón, D.; Padrós, F. Viral nervous necrosis in gilthead sea bream (Sparus aurata) caused by reassortant betanodavirus RGNNV/SJNNV: An emerging threat for Mediterranean aquaculture. Sci. Rep. 2017, 7, 46755. [Google Scholar] [CrossRef] [PubMed]
- Ge, H.; Lin, K.; Zhou, C.; Lin, Q.; Zhang, Z.; Wu, J.; Zheng, L.; Yang, Q.; Wu, S.; Chen, W.; et al. A multi-omic analysis of orange-spotted grouper larvae infected with nervous necrosis virus identifies increased adhesion molecules and collagen synthesis in the persistent state. Fish Shellfish Immunol. 2020, 98, 595–604. [Google Scholar] [CrossRef] [PubMed]
- Nishizawa, T.; Furuhashi, M.; Nagai, T.; Nakai, T.; Muroga, K. Genomic classification of fish nodaviruses by molecular phylogenetic analysis of the coat protein gene. Appl. Environ. Microbiol. 1997, 63, 1633–1636. [Google Scholar] [CrossRef] [PubMed]
- Bradley, R.J.; Pober, S.J. Tumor necrosis factor receptor-associated factors (TRAFs). Oncogene 2001, 20, 6482–6491. [Google Scholar] [CrossRef]
- Lalani, A.I.; Zhu, S.; Gokhale, S.; Jin, J.; Xie, P. TRAF Molecules in Inflammation and Inflammatory Diseases. Curr. Pharmacol. Rep. 2017, 4, 64–90. [Google Scholar] [CrossRef]
- Zotti, T.; Vito, P.; Stilo, R. The seventh ring: Exploring TRAF7 functions. J. Cell. Physiol. 2011, 227, 1280–1284. [Google Scholar] [CrossRef]
- Xie, P. TRAF molecules in cell signaling and in human diseases. J. Mol. Signal. 2013, 8, 7. [Google Scholar] [CrossRef] [PubMed]
- Park, H.H. Structure of TRAF Family: Current Understanding of Receptor Recognition. Front. Immunol. 2018, 9, 1999. [Google Scholar] [CrossRef]
- Deshaies, R.J.; Joazeiro, C.A. RING Domain E3 Ubiquitin Ligases. Annu. Rev. Biochem. 2009, 78, 399–434. [Google Scholar] [CrossRef] [PubMed]
- Häcker, H.; Tseng, P.-H.; Karin, M. Expanding TRAF function: TRAF3 as a tri-faced immune regulator. Nat. Rev. Immunol. 2011, 11, 457–468. [Google Scholar] [CrossRef]
- Deng, C.-C.; Zhu, D.-H.; Chen, Y.-J.; Huang, T.-Y.; Peng, Y.; Liu, S.-Y.; Lu, P.; Xue, Y.-H.; Xu, Y.-P.; Yang, B.; et al. TRAF4 Promotes Fibroblast Proliferation in Keloids by Destabilizing p53 via Interacting with the Deubiquitinase USP10. J. Investig. Dermatol. 2019, 139, 1925–1935.e5. [Google Scholar] [CrossRef]
- Regnier, C.; Tomasetto, C.; Moog-Lutz, C.; Chenard, M.-P.; Wendling, C.; Basset, P.; Rio, M.-C. Presence of a New Conserved Domain in CART1, a Novel Member of the Tumor Necrosis Factor Receptor-associated Protein Family, Which Is Expressed in Breast Carcinoma. J. Biol. Chem. 1995, 270, 25715–25721. [Google Scholar] [CrossRef] [PubMed]
- Kedinger, V.; Rio, M.-C. TRAF4, the Unique Family Member. Atherosclerosis 2007, 597, 60–71. [Google Scholar]
- Li, W.; Peng, C.; Lee, M.-H.; Lim, D.; Zhu, F.; Fu, Y.; Yang, G.; Sheng, Y.; Xiao, L.; Dong, X.; et al. TRAF4 Is a Critical Molecule for Akt Activation in Lung Cancer. Cancer Res. 2013, 73, 6938–6950. [Google Scholar] [CrossRef] [PubMed]
- Zhang, L.; Zhou, F.F.; de Vinuesa, A.G.; de Kruijf, E.M.; Mesker, W.E.; Hui, L.; Drabsch, Y.; Li, Y.H.; Bauer, A.; Rousseau, A.; et al. TRAF4 Promotes TGF-beta Receptor Signaling and Drives Breast Cancer Metastasis. Mol. Cell 2013, 51, 559–572. [Google Scholar] [CrossRef] [PubMed]
- Regnier, C.; Masson, R.; Kedinger, V.; Textoris, J.; Stoll, I.; Chenard, M.-P.; Dierich, A.; Tomasetto, C.; Rio, M.-C. Impaired neural tube closure, axial skeleton malformations, and tracheal ring disruption in TRAF4-deficient mice. Proc. Natl. Acad. Sci. USA 2002, 99, 5585–5590. [Google Scholar] [CrossRef]
- Ye, X.; Mehlen, P.; Rabizadeh, S.; Van Arsdale, T.; Zhang, H.; Shin, H.; Wang, J.J.L.; Leo, E.; Zapata, J.; Hauser, C.A.; et al. TRAF Family Proteins Interact with the Common Neurotrophin Receptor and Modulate Apoptosis Induction. J. Biol. Chem. 1999, 274, 30202–30208. [Google Scholar] [CrossRef] [PubMed]
- Esparza, E.M.; Arch, R.H. TRAF4 functions as an intermediate of GITR-induced NF-kappaB activation. Cell. Mol. Life Sci. 2020, 61, 3087–3092. [Google Scholar] [CrossRef] [PubMed]
- Li, K.-M.; Li, M.; Wang, N.; Chen, Y.-D.; Xu, X.-W.; Xu, W.-T.; Wang, L.; Chen, S.-L. Genome-wide identification, characterization, and expression analysis of the TRAF gene family in Chinese tongue sole (Cynoglossus semilaevis). Fish Shellfish Immunol. 2020, 96, 13–25. [Google Scholar] [CrossRef]
- Kim, W.L.; Kim, M.S.; Kim, K.H. Molecular cloning of rock bream’s (Oplegnathus fasciatus) tumor necrosis factor receptor-associated factor 2 and its role in NF-kappaB activation. Fish Shellfish Immunol. 2011, 30, 1178–1783. [Google Scholar] [CrossRef] [PubMed]
- Wei, J.; Guo, M.; Gao, P.; Ji, H.; Li, P.; Yan, Y.; Qin, Q. Isolation and characterization of tumor necrosis factor receptor-associated factor 6 (TRAF6) from grouper, Epinephelus tauvina. Fish Shellfish Immunol. 2014, 39, 61–68. [Google Scholar] [CrossRef]
- Lv, H.; Dong, W.; Guo, K.; Jin, M.; Li, X.; Li, C.; Zhang, Y. Tumor Necrosis Factor Receptor-Associated Factor 5 Interacts with the NS3 Protein and Promotes Classical Swine Fever Virus Replication. Viruses 2018, 10, 305. [Google Scholar] [CrossRef] [PubMed]
- Li, C.; Wei, J.; Zhang, X.; Sun, M.; Wu, S.; Qin, Q. Fish TRAF2 promotes innate immune response to RGNNV infection. Fish Shellfish Immunol. 2020, 102, 108–116. [Google Scholar] [CrossRef]
- Li, C.; Song, L.; Tan, F.; Su, B.; Zhang, D.; Zhao, H.; Peatman, E. Identification and mucosal expression analysis of cathepsin B in channel catfish (Ictalurus punctatus) following bacterial challenge. Fish Shellfish Immunol. 2015, 47, 751–757. [Google Scholar] [CrossRef]
- Wei, T.; Sun, Y.; Shi, G.; Wang, R.; Xu, T. Characterization and SNP variation analysis of a HSP70 gene from miiuy croaker and its expression as related to bacterial challenge and heat shock. Fish Shellfish Immunol. 2012, 33, 632–640. [Google Scholar] [CrossRef] [PubMed]
- Khan, K.A.; Abbas, W.; Varin, A.; Kumar, A.; Di Martino, V.; Dichamp, I.; Herbein, G. HIV-1 Nef Interacts with HCV Core, Recruits TRAF2, TRAF5 and TRAF6, and Stimulates HIV-1 Replication in Macrophages. J. Innate Immun. 2013, 5, 639–656. [Google Scholar] [CrossRef] [PubMed]
- Zhang, X.; Wen, Z.; Sun, L.; Wang, J.; Song, M.; Wang, E.; Mi, X. TRAF2 regulates the cytoplasmic/nuclear distribution of TRAF4 and its biological function in breast cancer cells. Biochem. Biophys. Res. Commun. 2013, 436, 344–348. [Google Scholar] [CrossRef] [PubMed]
- Kedinger, V.; Alpy, F.; Baguet, A.; Polette, M.; Stoll, I.; Chenard, M.P.; Tomasetto, C.; Rio, M.C. Tumor Necrosis Factor Receptor-Associated Factor 4 Is a Dynamic Tight Junction-Related Shuttle Protein Involved in Epithelium Homeostasis. PLoS ONE 2008, 3, e3518. [Google Scholar] [CrossRef]
- Camilleri-Broet, S.; Cremer, I.; Marmey, B.; Comperat, E.; Viguié, F.; Audouin, J.; Rio, M.-C.; Fridman, W.-H.; Sautès-Fridman, C.; Régnier, C.H.; et al. TRAF4 overexpression is a common characteristic of human carcinomas. Oncogene 2006, 26, 142–147. [Google Scholar] [CrossRef] [PubMed]
- Dempsey, P.W.; Doyle, S.E.; He, J.Q.; Cheng, G. The signaling adaptors and pathways activated by TNF superfamily. Cytokine Growth Factor Rev. 2003, 14, 193–209. [Google Scholar] [CrossRef]
- Yuan, S.; Liu, T.; Huang, S.; Wu, T.; Huang, L.; Liu, H.; Tao, X.; Yang, M.; Wu, K.; Yu, Y.; et al. Genomic and Functional Uniqueness of the TNF Receptor-Associated Factor Gene Family in Amphioxus, the Basal Chordate. J. Immunol. 2009, 183, 4560–4568. [Google Scholar] [CrossRef] [PubMed]
- Wei, J.; Li, C.; Ou, J.; Zhang, X.; Liu, Z.; Qin, Q. The roles of grouper TANK in innate immune defense against iridovirus and nodavirus infections. Fish Shellfish Immunol. 2020, 104, 506–516. [Google Scholar] [CrossRef]
- Huang, X.H.; Huang, Y.H.; Sun, J.J.; Han, X.; Qin, Q. Characterization of two grouper Epinephelus akaara cell lines: Application to studies of Singapore grouper iridovirus (SGIV) propagation and virus-host interaction. Aquaculture 2009, 292, 172–179. [Google Scholar] [CrossRef]
- Wei, J.; Zhang, X.; Zang, S.; Qin, Q. Expression and functional characterization of TRIF in orange-spotted grouper (Epinephelus coioides). Fish Shellfish Immunol. 2017, 71, 295–304. [Google Scholar] [CrossRef] [PubMed]
- Li, C.; Liu, J.; Zhang, X.; Wei, S.; Huang, X.; Huang, Y.; Wei, J.; Qin, Q. Fish Autophagy Protein 5 Exerts Negative Regulation on Antiviral Immune Response Against Iridovirus and Nodavirus. Front. Immunol. 2019, 10, 517. [Google Scholar] [CrossRef] [PubMed]

| Name | Sequence (5′–3′) |
|---|---|
| RGNNV-CP-RT-F | CAACTGACAACGATCACACCTTC |
| RGNNV-CP-RT-R | CAATCGAACACTCCAGCGACA |
| RGNNV-RdRp-RT-F | GTGTCCGGAGAGGTTAAGGATG |
| RGNNV-RdRp-RT-R | CTTGAATTGATCAACGGTGAACA |
| EcTRAF4-RT-F | TTCAGCCCACCCTTCTACACTCA |
| EcTRAF4-RT-R | CCACTCCAGCAGGTTGTCGTACTCT |
| β-actin-RT-F β-actin-RT-R | TACGAGCTGCCTGACGGACA GGCTGTGATCTCCTTCTGCA |
| EcISG15-RT-F | CCTATGACATCAAAGCTGACGAGAC |
| EcISG15-RT-R | GTGCTGTTGGCAGTGACGTTGTAGT |
| EcISG56-RT-F | CTGTTGTTACGCACGGAGGAT |
| EcISG56-RT-R | CCTGCGTGGGTTCATTCAGT |
| EcIFN2-RT-S | TACAGCCAGGCGTCCAAAGCATC |
| EcIFN2-RT-R | CAGTACAGGAGCGAAGGCCGACA |
| EcIL-1β-RT-F | AACCTCATCATCGCCACACA |
| EcIL-1β-RT-R | AGTTGCCTCACAACCGAACAC |
| EcIL8-RT-F | GCCGTCAGTGAAGGGAGTCTAG |
| EcIL8-RT-R | ATCGCAGTGGGAGTTTGCA |
| EcTNFα-RT-F | GTGTCCTGCTGTTTGCTTGGTA |
| EcTNFα-RT-R | CAGTGTCCGACTTGATTAGTGCTT |
| EcTRAF6-RT-F | CCCTATCTGCCTTATGGCTTTGA |
| EcTRAF6-RT-R | ACAGCGGACAGTTAGCGAGAGTAT |
| Name | Sequence (5′–3′) | Usage |
|---|---|---|
| F1 | ATGCCCGGGTTTGATTACAAGTTTC | EcTRAF4 cloning |
| R1 | TTAAGCCATGATCTTCTGGGGAATC | |
| C1-EcTRAF4-F C1-EcTRAF4-R | GCCTCGAGCTATGCCCGGGTTTGATTAC GCGGATCCTTAAGCCATGATCTTCTGG | pEGFP-C1 cloning |
| HA-EcTRAF4-F | GCGGATCCTATGCCCGGGTTTGATTAC | pcDNA3.1-3HA cloning |
| HA-EcTRAF4-R | GCCTCGAGTTAAGCCATGATCTTCTGG | |
| HA-CP-F | GCAAGCTTATGGTACGCAAAGGTGAGAAGAAAT | pcDNA3.1-3HA cloning |
| HA-CP-R | GCGAATTCGTTTTCCGAGTCAACCCTGGTGCAG |
Publisher’s Note: MDPI stays neutral with regard to jurisdictional claims in published maps and institutional affiliations. |
© 2021 by the authors. Licensee MDPI, Basel, Switzerland. This article is an open access article distributed under the terms and conditions of the Creative Commons Attribution (CC BY) license (https://creativecommons.org/licenses/by/4.0/).
Share and Cite
Wu, S.; Sun, M.; Zhang, X.; Liao, J.; Liu, M.; Qin, Q.; Wei, J. Grouper TRAF4, a Novel, CP-Interacting Protein That Promotes Red-Spotted Grouper Nervous Necrosis Virus Replication. Int. J. Mol. Sci. 2021, 22, 6136. https://doi.org/10.3390/ijms22116136
Wu S, Sun M, Zhang X, Liao J, Liu M, Qin Q, Wei J. Grouper TRAF4, a Novel, CP-Interacting Protein That Promotes Red-Spotted Grouper Nervous Necrosis Virus Replication. International Journal of Molecular Sciences. 2021; 22(11):6136. https://doi.org/10.3390/ijms22116136
Chicago/Turabian StyleWu, Siting, Mengshi Sun, Xin Zhang, Jiaming Liao, Mengke Liu, Qiwei Qin, and Jingguang Wei. 2021. "Grouper TRAF4, a Novel, CP-Interacting Protein That Promotes Red-Spotted Grouper Nervous Necrosis Virus Replication" International Journal of Molecular Sciences 22, no. 11: 6136. https://doi.org/10.3390/ijms22116136
APA StyleWu, S., Sun, M., Zhang, X., Liao, J., Liu, M., Qin, Q., & Wei, J. (2021). Grouper TRAF4, a Novel, CP-Interacting Protein That Promotes Red-Spotted Grouper Nervous Necrosis Virus Replication. International Journal of Molecular Sciences, 22(11), 6136. https://doi.org/10.3390/ijms22116136
